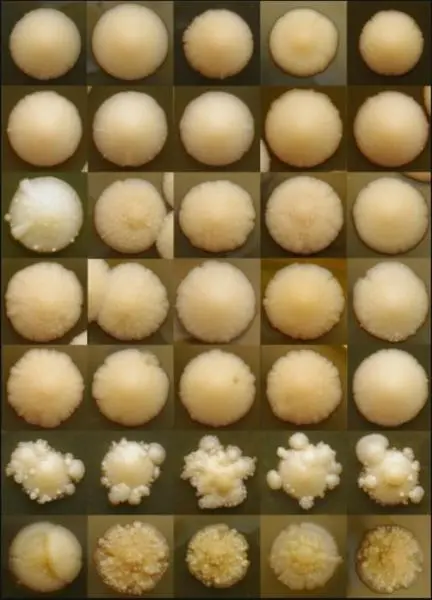

Az elmúlt évtizedekben a predesztináló tényezők számának növekedésével és elterjedésével párhuzamosan emelkedett a Candida fajok által okozott felületi és invazív megbetegedések gyakorisága Így célunk az opportunista patogén Candida fajok patogenezisének vizsgálata biológiai, biokémiai, transzkriptomikai és bioinformatikai módszerekkel. Új terápiás célpontok azonosítása és jellemzése, valamint hatékonyabb antifungális terápiák kifejlesztése a Candida fajok által okozott infekciók kezelésére.


Élesztőgombák diverzitása, taxonómiája. Gombák a mikrobiomban, élesztő probiotikumok. Gombák domesztikációs története, élelmiszeripari és patogén/kommenzalista gombák komparatív genomikája és mikroevolúciója. Mikotoxintermelő gombák. Ízeltlábú-gomba koevolúciós kapcsolatok.

Gombák (elsősorban Aspergillus fajok) stresszválaszainak vizsgálata transzkriptomikai módszerek felhasználásával. Célunk - többek között - annak megértése, hogy hogyan képesek a gombák alkalmazkodni a környezetükben bekövetkezett változásokhoz, hogyan élnek túl olyan helyzetekben, amikor egyszerre több, nagyon eltérő stresszhatás éri őket és, hogy hogyan tudnak számukra „ismeretlen” környezethez is eredményesen elszaporodni.


A mikroszkopikus gombák élettani folyamatainak megismerése ipari, egészségügyi, ill. élelmiszer-egészségügyi szempontból jelentős. A laboratóriumban alkalmazott gombák számos természetes vegyület forrásai, az általuk termelt szekunder metabolitok szerkezeti felépítése, ill. biológiai funkciója igen változatos. Kutatásunk a szekunder metabolit könyvtár bővítése céljából ezen másodlagos anyagcsere termékek kémiai azonosítására fókuszál. Szerves kémiai labor műveletek, kiterjedt analitikai rendszerek, ill. spektroszkópiai módszerek segítségével molekulaszerkezetük jól definiálható.
Az általunk folytatott interdiszciplináris kutatások számos tudományterület eszköztárát felhasználva vizsgálják a celluláris rendszerek időbeli változásait. Alap- és alkalmazott kutatásaink során noninvazív időbeli képalkotó módszereket használunk, az általunk kifejlesztett közeli infravörös hullámhossz tartományú műszerbázist alkalmazva.


Kis molekulatömegű antifungális fehérjék jellemzése.
A mitokondrium integritás szerepe a fonalas gombák élettartamában.

Állatkísérletek végzése tüdőaszpergillózis egérmodellen.


Új vegyületek antifungális hatásának in vitro és in vivo tesztelése.